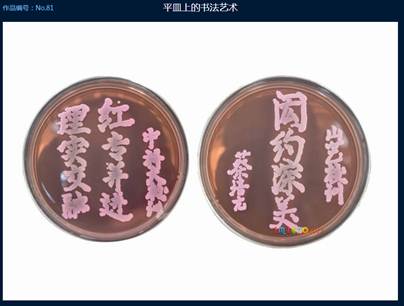

由我校研究生院主办,生命科学实验中心、理化科学实验中心承办,安徽省细胞学会、安徽省电镜学会协办的中国科学技术大学第二届“显微摄影比赛”颁奖仪式于6月2日下午在生命科学学院学术报告厅举行。我校研究生院、公共实验中心、生命学院相关负责人出席颁奖仪式并为获奖作者颁奖。



本次显微摄影比赛以“发现微观之美,分享科研之趣”为主题,旨在充分展示与众不同的微观世界的美丽画卷,发掘科学研究工作中的非凡乐趣,为从事相关研究领域的老师和同学搭建一个展示和交流的平台,对培养研究生在科研活动中的创新意识,提高实验动手能力,推动我校先进显微影像仪器设备在科研工作中的高水平应用起到了促进作用。
比赛受到了中国科学技术大学各院系、安徽省相关高校以及科研院所的广泛关注和积极参与。比赛共征集参赛作品163幅,图片数量及质量较第一届相比,都有了较大提高。高水平的参赛作品不但得到了广大师生的赞赏,也吸引了社会观众与新闻媒体的关注。《新安晚报》撰文《放大千万倍,铁锈也“开花”》和《1元银色硬币显微镜下发“绿光”》对此次活动进行了专门报道。

本次活动于今年4月开始面向全校及省内各高校和科研院所征集作品。参赛作品展示期间,还进行了公众现场投票和网络投票。同时比赛还邀请了来自校内外相关研究领域的专家,对参赛作品做了认真评审。综合专家评审和投票结果,共评出一等奖、二等奖、三等奖25名。
(研究生院、公共实验中心、生命科学学院)
附第二届显微摄影比赛网址:
http://imicro.ustc.edu.cn/